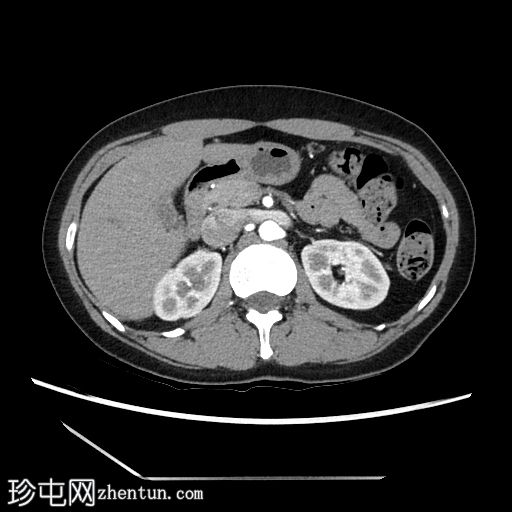
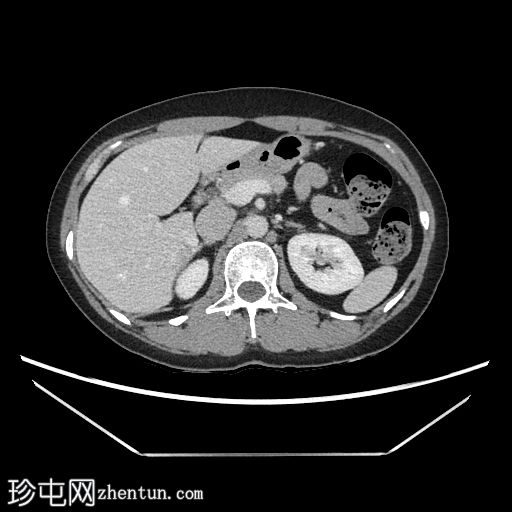
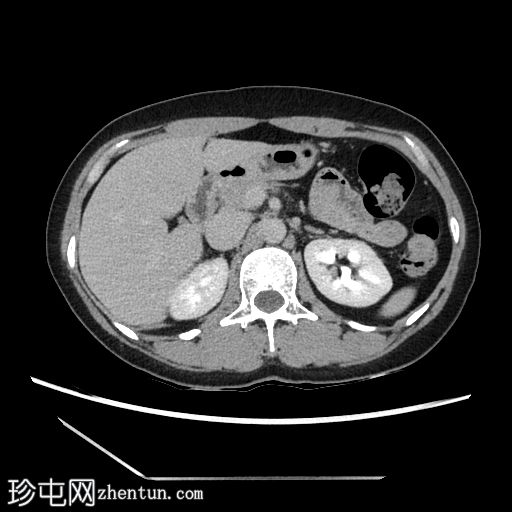

病情描述
胸部CT检查是肉瘤分期检查的一部分,检查过程中偶然发现了肝脏病变。腹部超声检查提示可能存在肝腺瘤,提示需要进一步检查。随后,患者进行了腹部和盆腔CT检查,以评估肝脏病变。
患者资料
年龄:40岁
性别:女
CT扫描

轴向
非造影
轴向C+期
动脉期
轴向C+期
门静脉期
轴向C+期
延迟

冠状面
非造影

冠状面C+期
动脉期

门静脉期
冠状面C+期

延迟
矢状面

非造影
矢状面C+期

动脉期
矢状面C+期

门静脉期
矢状面C+期

延迟
在轴向、冠状面和矢状面上均可见肝5/6段病变。动脉期可见周围结节状强化,门静脉期可见进行性向心性充盈,延迟期亦持续存在。这些表现为肝血管瘤的特征性表现。
病例讨论
先前的超声检查将肝腺瘤纳入了鉴别诊断。
然而,目前的CT扫描显示动脉期呈周围结节性强化,门静脉期呈进行性向心性充盈,且延迟成像后仍持续存在。这些特征是肝血管瘤的特征。未发现其他肝脏病变。
本研究发现了一个偶然发现的肝血管瘤。
肝血管瘤是最常见的肝脏良性肿瘤,无恶性潜能。 |